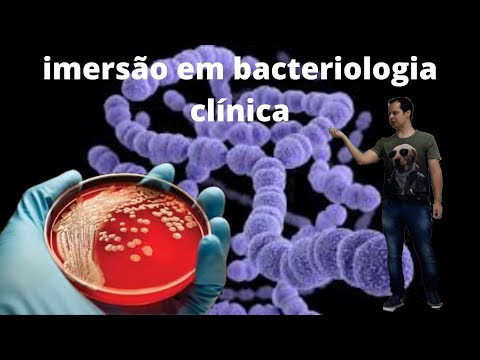
YouTube Placeholder

Informações técnicas Imersão em Bacteriologia Clínica 1.0
:background_color(white)/hotmart/product_contents/80dbba9b-0fd9-4e04-b7f9-b64bb256354f/pp.jpg)
- Autor:
- Residência Biomédica
- Avaliação dos Alunos
- 5.00 ⭐
- Plataforma
- Hotmart
- Garantia
- 7 Dias na Hotmart
- Emite certificado?
- Sim
- Link de Acesso
- Acesse Aqui
Usamos cookies para melhorar sua experiência. Ao continuar navegando, você concorda com nossa
Política de Privacidade.